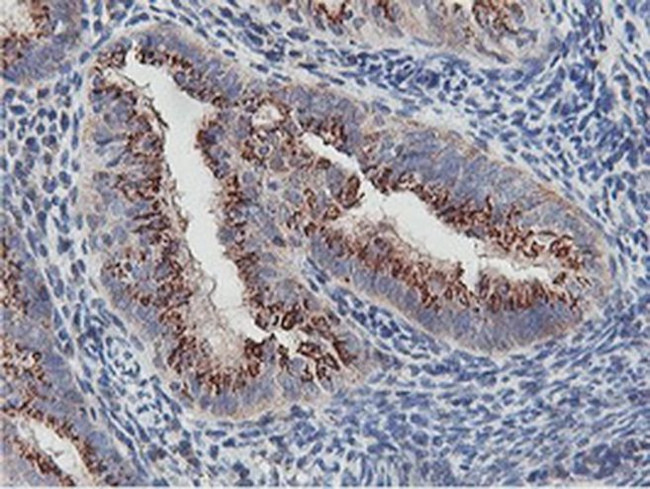
NMT2 Antibody in Immunohistochemistry (Paraffin) (IHC (P))

Search
Invitrogen
NMT2 Monoclonal Antibody (OTI1G3)
{{$productOrderCtrl.translations['antibody.pdp.commerceCard.promotion.promotions']}}
{{$productOrderCtrl.translations['antibody.pdp.commerceCard.promotion.viewpromo']}}
{{$productOrderCtrl.translations['antibody.pdp.commerceCard.promotion.promocode']}}: {{promo.promoCode}} {{promo.promoTitle}} {{promo.promoDescription}}. {{$productOrderCtrl.translations['antibody.pdp.commerceCard.promotion.learnmore']}}
图: 1 / 6
NMT2 Antibody (MA5-25836) in IHC (P)






Please note: We are reviewing Western blot images included in the antibody testing data in our catalog, including those provided by third parties. Unless expressly labeled or annotated as “raw-unedited”, Western blot images included in the antibody testing data in our catalog may have been edited, optimized or otherwise adjusted for presentation.
产品信息
MA5-25836
种属反应
宿主/亚型
分类
类型
克隆号
抗原
偶联物
形式
浓度
规格
纯化类型
保存液
内含物
保存条件
运输条件
RRID
靶标信息
Proteolytic degradation is critical to the maintenance of appropriate levels of short-lived and regulatory proteins as important and diverse as those involved in cellular metabolism, heat shock and stress response, antigen presentation, modulation of cell surface receptors and ion channels, cell cycle regulation, transcription, and signaling factors. The ubiquitin-proteasome pathway deconstructs most proteins in the eukaryotic cell cytosol and nucleus. Others are degraded via the vacuolar pathway which includes endosomes, lysosomes, and the endoplasmic reticulum. The 26S proteasome is an ATP-dependent, multisubunit (approximately 31), barrel-shaped molecular machine with an apparent molecular weight of approximately 2.5 MDa. It consists of a 20S proteolytic core complex which is crowned at one or both ends by 19S regulatory subunit complexes. The 19S regulatory subunits recognize ubiquitinated proteins and play an essential role in unfolding and translocating targets into the lumen of the 20S subunit. An enzymatic cascade is responsible for the attachment of multiple ubiquitin molecules to lysine residues of proteins targeted for degradation. Several genetic diseases are associated with defects in the ubiquitin-proteasome pathway. Some examples of affected proteins include those linked to cystic fibrosis, Angelman's syndrome, and Liddle syndrome.
仅用于科研。不用于诊断过程。未经明确授权不得转售。
篇参考文献 (0)
生物信息学
蛋白别名: Glycylpeptide N-tetradecanoyltransferase 2; Myristoyl-CoA:protein N-myristoyltransferase 2; NMT 2; Peptide N-myristoyltransferase 2; Protein-lysine myristoyltransferase NMT2; Type II N-myristoyltransferase
基因别名: NMT2
Entrez Gene ID: (Human) 9397